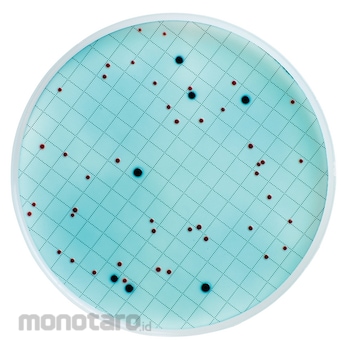
main product photo

Merck Millipore M-Coliblue - Coliform Detection Medium 1unit
Rp4.799.900
Persediaan
Spesifikasi Produk
| Unit | 1unit |
|---|---|
| Applicable Device | MF-methodMicrofilMilliflexMicropreSure |
| Type of Test | Microbial LimitsBioburden TestingWater Monitoring |
| Quality Level | MQ100 |
| Pre-filled agar media | m-ColiBlue |
| Target Microorganisms | Coliform, E.coli |
| Incubation Temperature | 35 °C ± 0.5 |
| Incubation Time | 24 hrs |
| Media Color | Blue |
| Media Form | Liquid |
| Volume (ml) | 2 |
| Certificate Included | Y |
| Regulatory Conformance | EPA ; Standard Methods for the Examination of Water and Wastewater |
| Storage Temperature | 2 to 8 °C |
| Shelf Life | 12 months |
| Number Tests/Pk | 50 |
| Berat (Kg) | 2.2 |
| Tanggal Produk Terdaftar | 21 July 2020 |
| Terakhir Diperbaharui | 27 May 2025 |
Informasi Produk
Description
ColiBlue24 Broth Overview Cpatible with Absorbent Pads EO sterilized its AP10047E0 orilliflex Liquidedia Cassette. Do not use Gma sterilizedillipore its. Application For testing drinking water and bient water. Total colifo and E. coli detection. Beer, Bottled Water, Cider, Soft Drink, Sport Drink, Wine Key Applications ClinicalCoeticsEnviroental AnalysisFood and BeverageIndustrial QC Organi Appearance E.coli fos blue colonies. Other colifos will show as red colonies. All other colors are nocolifo bacteria.
Ketentuan dan Kondisi Barang
Pengembalian Barang 14 hari
Berubah pikiran tidak dapat diterima. Lihat selengkapnya
GRATIS ONGKIR* ke Jabodetabek, Banten,
Jabar & Jatim dengan minimum total pesanan Rp200.000 saat checkout. Lihat selengkapnya
Jabar & Jatim dengan minimum total pesanan Rp200.000 saat checkout. Lihat selengkapnya
Pilih jenis produk yang diinginkan
| Nomor SKU | Model Number | Masa Persiapan Barang | Harga | Jumlah |
|---|---|---|---|---|
| Loading... | ||||
Ulasan Produk
Tidak ada ulasan